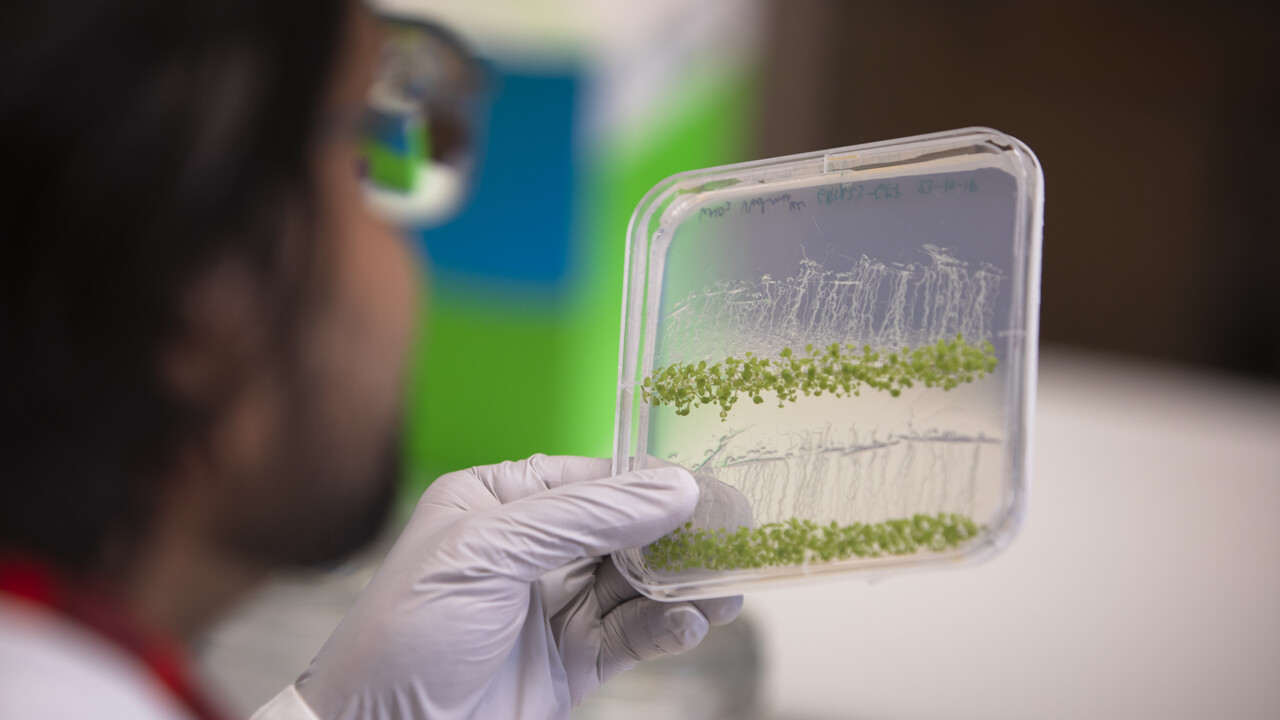
Dhruv Agrawal

Short facts about Dhruv
Comes from: India
Me in three words: Passionate, simple, organized
Interests: Music, sketching and movies
Favourite book: The perks of being a wallflower by Stephen Chbosky
Streaming: Biopics (biographical movies)
Listening to: Country music
Miss from home: Street food from the local vendors
The first Swedish word I learnt: Vatten
On my bucket list: Learn scuba diving
Favourite holiday spot: Summer evenings on the beach
Enjoy: Cooking, and it saddens me when I see the food go to waste